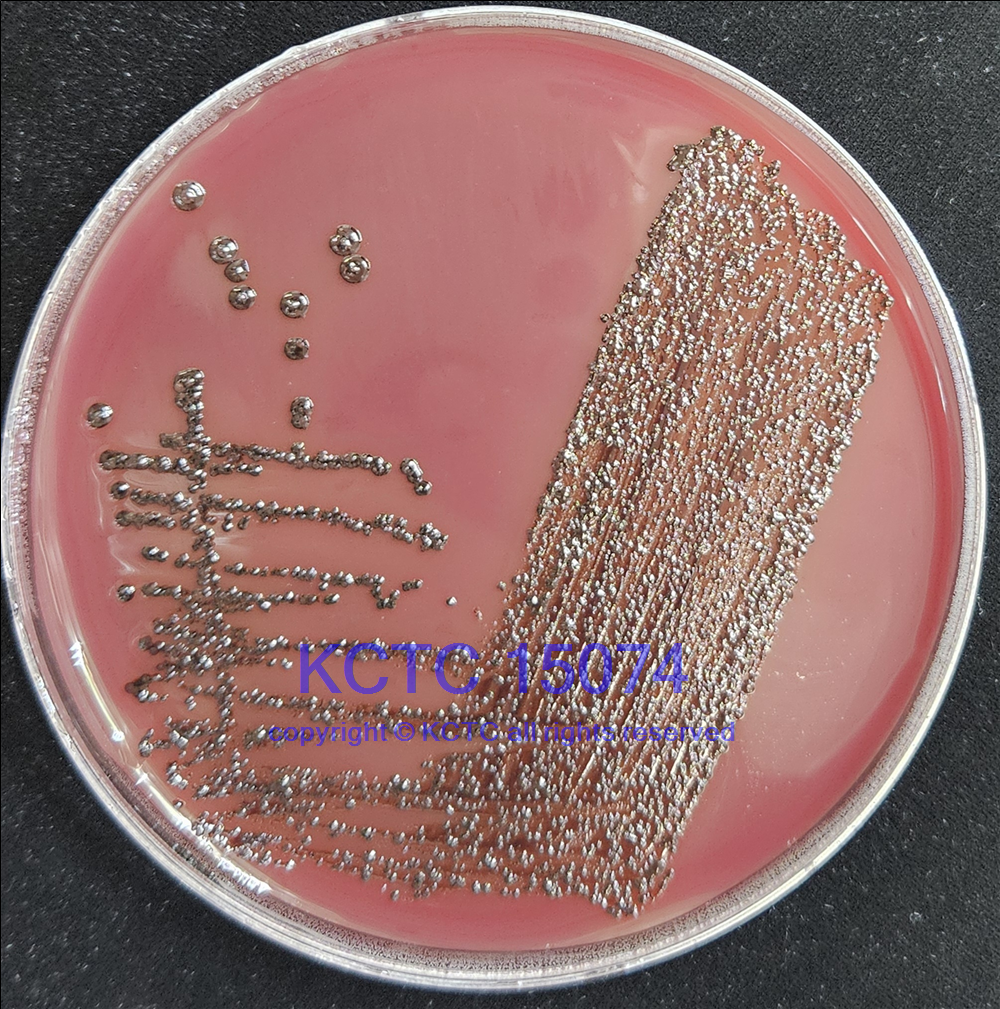

KCTC No. 15074
(KCTC Other No.)
Resource Type Bacteria
Name Prevotella falsenii
Type Strain Yes
Biosafty Level 1
LMO No
Synonym
Phylum (ex Phylum) Bacteroidota (Bacteroidetes)
Genome Information
NCBI Genome UID : GCA_000613945.1
JGI Genome ID : Gp0092042
History <- JCM <- M Sakamoto, 04052 <- H Kumada, Pi 04052
Source From monkey dental plaque(male long-tailed macaques, 5-6 years old), Japan
Other Collection No. 04052, CCUG [56137], DSM [22864], JCM [15124]
Reference 10.1099/ijs.0.002626-0
KCTC Media No. KCTC media No. 293 EG Medium
Oxygen Requirement Anaerobic
Temperature 37 ℃
pH netural pH ?? ?? (???? ??)
Incubation Time 3-4d [???? ???? ????? ??, ?? ? ????? ??? ?? ?? ? ??]